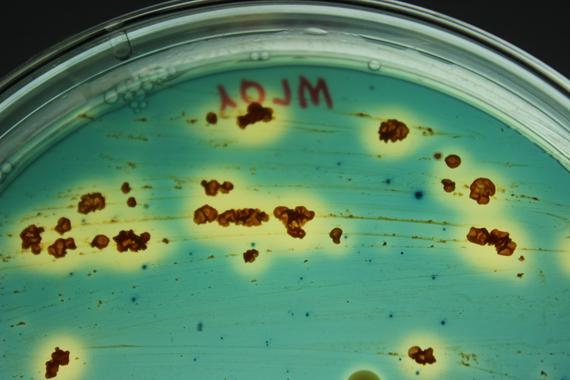

Ya en 2010 el equipo de Martha Trujillo, investigadora del departamento de microbiología y genética de la Universidad de Salamanca, revolucionó el estudio de las interacciones entre plantas y microorganismos al publicar un artículo que revelaba la presencia de Micromonospora en las raíces de las leguminosas, cuando los expertos pensaban que en ellas sólo había microorganismos del género Rhizobium, que forman nódulos y ayudan a fijar nitrógeno, un nutriente esencial.
Ya en 2010 el equipo de Martha Trujillo, investigadora del departamento de microbiología y genética de la Universidad de Salamanca, revolucionó el estudio de las interacciones entre plantas y microorganismos al publicar un artículo que revelaba la presencia de Micromonospora en las raíces de las leguminosas, cuando los expertos pensaban que en ellas sólo había microorganismos del género Rhizobium, que forman nódulos y ayudan a fijar nitrógeno, un nutriente esencial.
«Creemos que esta nueva interacción entre planta y microorganismo es beneficiosa para ambos», apunta la científica en declaraciones a DiCYT. Por eso, su grupo lleva años trabajando en esta línea de investigación y ha conseguido aislar hasta 2.000 cepas de esta actinobacteria de distintas leguminosas. Sin embargo, era necesario realizar un estudio molecular «para ver cómo lo podemos aprovechar en campos como la agricultura y la biotecnología» y eso es lo que han hecho en un trabajo publicado ahora en la revista PLOS ONE.
En concreto, los investigadores han tomado como modelo Micromonospora lupini Lupac 08, la cepa que tienen mejor estudiada y que cuenta con casi 7.000 genes, una cifra muy alta para una bacteria.
Uno de los aspectos más importantes del trabajo es intentar averiguar cuáles de esos genes son importantes para la interacción con su hospedador y en este punto la secuenciación ha revelado una gran sorpresa: casi 200 codifican enzimas que destruyen tejido vegetal, lo cual resulta paradójico en una bacteria que se encuentra en el interior de las plantas y que favorece su protección y crecimiento, según han demostrado anteriores estudios.
«Un microorganismo que produce tantas enzimas que degradan el tejido vegetal se puede considerar, en principio, más patógeno que beneficioso», apunta Martha Trujillo. De hecho, las bacterias endófitas, es decir, las que viven en el interior de la planta, como Micromonospora, tienen una cantidad muy baja o inexistente de ellas. Por eso, los científicos consideran que «la planta debe tener algún mecanismo para reprimir estos genes».
Posible adaptación a la vida endófita
Este curioso aspecto de la investigación tiene otra consecuencia recogida por el artículo de PLOS ONE. El equipo de Martha Trujillo maneja la hipótesis de que esta bacteria, que también se puede encontrar en el suelo, se está adaptando a vivir en el interior de las plantas. Existe otro género de microorganismos denominado Francia del que ya se han secuenciado tres cepas cuyo tamaño del genoma era muy diferente.
«La cepa que tenía un genoma más pequeño había perdido los genes que le servían para vivir fuera de la planta, pero se había habituado a la vida endofítica y ahora ya no los necesitaba», señala la experta, que piensa que puede suceder lo mismo con Micromonospora.
Para comprobar si es así y seguir avanzando en otros aspectos de esta investigación, los investigadores tienen previsto secuenciar al menos una docena de genomas más, lo que permitirá obtener una buena base de datos y deducir cuáles son los genes comunes fundamentales en la relación entre planta y microorganismo. Posteriormente, también abordarán estudios de transcriptómica para comprobar cuáles son los genes que se expresan en dicha interacción.
Este último aspecto puede tener importantes aplicaciones biotecnológicas, porque Micromonospora produce moléculas que ayudan a proteger a la planta de otros microorganismos patógenos. De hecho, este tipo de investigación, aparte del interés científico, está muy orientada a obtener aplicaciones en agricultura, ya que incorporar microorganismos beneficiosos para los cultivos evitaría tener que usar productos químicos. En este caso, esta bacteria unida a Rhizomium hace que las plantas multipliquen su crecimiento en algunos ensayos.
Por otra parte, el análisis de los genes de esta bacteria también tendrá consecuencias para la taxonomía de este género de microorganismos. «Queremos basar toda la clasificación en la información de los genomas», señala la investigadora. Los científicos salmantinos han descrito ya seis especies nuevas de Micromonospora, pero consideran que este nuevo trabajo supone un hito importante en su línea de investigación.
Además de los investigadores de la Universidad de Salamanca, firman el artículo científicos de Francia y Japón con los que colaboran habitualmente. La secuenciación del genoma de esta cepa se tuvo que realizar en Alemania, pero en la actualidad el institución académica salmantina ya cuenta con un avanzado equipo en el Servicio de Secuenciación de ADN, Genómica y Proteómica de la Plataforma NUCLEUS para realizar este trabajo y se está poniendo en marcha un nuevo servicio de bioinformática que permita analizar los datos.
Referencia bibliográfica:
Genome Features of the Endophytic Actinobacterium Micromonospora lupiniStrain Lupac 08: On the Process of Adaptation to an Endophytic Life Style? Martha E. Trujillo, Rodrigo Bacigalupe, Petar Pujic, Yasuhiro Igarashi, Patricia Benito, Raúl Riesco, Claudine Médigue, Philippe Normand. PLOS ONE, 2014 Sep 30;9(9):e108522. DOI: 10.1371/journal.pone.0108522
Fuente: DiCYT